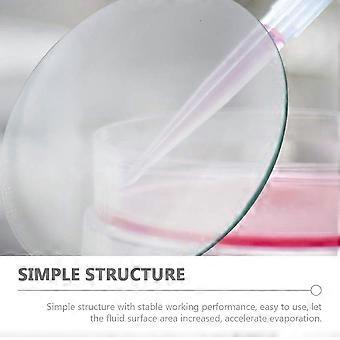
product image

10pcs Laboratory Watch Glasses Transparent Watch Glass Experiment Watch Glasses
ja 2,99 € toimitus

10pcs Laboratory Watch Glasses Transparent Watch Glass Experiment Watch Glasses
- Merkki: Unbranded
10pcs Laboratory Watch Glasses Transparent Watch Glass Experiment Watch Glasses
- Merkki: Unbranded
Tallenna 75,05 € (75%)
ovh.
14 päivän palautuskäytäntö
Tallenna 75,05 € (75%)
ovh.
14 päivän palautuskäytäntö
Maksutavat:
Kuvaus
10pcs Laboratory Watch Glasses Transparent Watch Glass Experiment Watch Glasses
- Merkki: Unbranded
- Kategoria: Kolvit
- Fruugo ID: 356245189-774403466
- EAN: 7413530509753
Tuoteturvallisuustiedot
Katso tätä tuotetta koskevat tuoteturvallisuustiedot alla
Seuraavat tiedot tarjoaa tätä tuotetta myyvä riippumaton kolmas osapuoli.
Tuoteturvallisuustarrat

Toimitus ja palautukset
Lähetetään 24 tunnin kuluessa
-
STANDARD: 2,99 € - Toimitus välillä pe 20 helmikuuta 2026–pe 27 helmikuuta 2026
Lähetyspaikka: Kiina.
Teemme parhaamme varmistaaksemme, että kaikki tilaamasi tuotteet toimitetaan sinulle toiveidesi mukaisesti. Jos sinulle toimitettu tilaus kuitenkin on puutteellinen tai sisältää tilaamattomia tuotteita, tai jos et jostain muusta syystä ole tyytyväinen tilaukseesi, voit palauttaa tilauksen kokonaan tai osittain. Saat tuotteista täyden hyvityksen. Näytä koko palautuskäytäntö
Tuotteen vaatimustenmukaisuustiedot
Katso tätä tuotetta koskevat yhteensopivuustiedot alla.
Seuraavat tiedot tarjoaa tätä tuotetta myyvä riippumaton kolmas osapuoli.
Valmistaja:
Alla oleva informaatio sisältää Fruugossa myytävän tuotteen valmistajan yhteystiedot.
- Shenzhen Huiwenzhong Technology Co., Ltd.
- Shenzhen Huiwenzhong Technology Co., Ltd.
- C205-R, Building C, No. 19 Yinzhu Road, Nanlian Community, Longgang Street, Longgang District, Shenzhen City
- Shenzhen
- CN
- 518000
- upleture@hotmail.com
- 19928320113
Vastuuhenkilö EU:ssa:
Alla oleva informaatio sisältää EU:n alueen vastuuhenkilön yhteystiedot. Vastuuhenkilö on EU:n alueella sijaitseva nimetty talouden toimija, joka on vastuussa asianomaisen EU:n alueelle myytävän tuotteen vaatimustenmukaisuudesta.
- EC REP SERVICES SL
- EC REP SERVICES SL
- Calle Gran Via 49, 7 Dch.
- Madrid
- ES
- 28013
- ecrepservice@hotmail.com
- 0034 910 5631 02